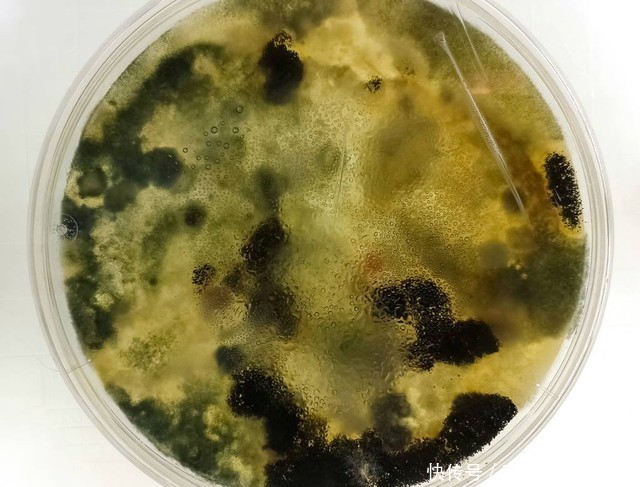

友情提示
本站部分转载文章,皆来自互联网,仅供参考及分享,并不用于任何商业用途;版权归原作者所有,如涉及作品内容、版权和其他问题,请与本网联系,我们将在第一时间删除内容!
联系邮箱:1042463605@qq.com
建议 :大便的状态就是身体的状态,你的大便才是身体的真正反馈
43
0
相关文章
最新文章
标签云
社会
便秘
腹泻
晨起
拉屎
肠胃
脂肪
泻药
益生元
黑势力
娱乐圈
减肥
海带
苹果
放射性物质
胡萝卜
心血管疾病
肠道
膳食纤维
西兰花
抗氧化物
菠菜
碱性食物
红薯
剁椒
芋头
饮食习惯
健康
代茶饮
雪梨
疾病
鲜奶
宝宝
奶粉
益生菌
可溶性纤维
金匮要略
大便
张仲景
中药
脱发
肾脏
阳气不足
中医
猕猴桃
火龙果
养生
癌细胞
早餐
脾胃
消化道出血
睡眠质量
一日三餐
日常饮食
猪油
不饱和脂肪酸
老年人
黑木耳
红枣
生态平衡
慢性疾病
肠道菌群
营养物质
血糖控制
生命之旅
三七粉
心脑血管
本草纲目
胃癌
肝功能检查
胆汁
胆红素
肝癌
肝脏
肝损伤
肥料
古代
肝硬化
病毒性肝炎
慢性肝炎
大肠癌
肿瘤
肠梗阻
胰腺癌
印度
加拿大
印度人
皮肤瘙痒
肠息肉
伤寒论
粳米
伤寒杂病论
血糖
空腹血糖
痔疮
恶性肿瘤
胃部
胃镜检查
脾胃虚寒
癌症
肠镜检查
心理健康
结直肠癌
高蛋白食物
直肠癌
吞咽困难
食管癌
消化道肿瘤
酸碱平衡
亲爱的
胃溃疡
胃黏膜
萎缩性胃炎
热量
胆结石
番茄
凉拌菜
西红柿
山楂
李子
十二指肠溃疡
东南亚地区
辣椒
饮食
咖啡因
睡眠障碍
尼古丁
炎症
肝气郁结
中风
慢性阻塞性肺疾病
苦瓜
金针菇
糖尿病患者
并发症
白酒
美好时光
幽门螺杆菌感染
醋泡姜
脂肪肝
慢性胃炎
健康食品
小米
慢性萎缩性胃炎
杨梅
体重指数
美国医学会杂志
高血压
肥胖
体重
瑜伽
中国工程院院士
游泳
锻炼
糖尿病
延缓衰老
b族维生素
甲状腺肿大
李明
维生素d
蛋白质
增强体质
心跳加速
睡眠时间
四世同堂
不良习惯
中南大学
优质蛋白
京都大学
步行者
英国医学杂志
美国国会
美国
前列腺癌
胰岛素
自然通讯
胰岛素抵抗
深度睡眠
高血脂
颈动脉斑块
血管
巴西
甲状腺激素
蘑菇
未成年人
牛肉
胶原蛋白
科学
失眠
安眠药
运动能力
关节
甲胎蛋白
华西医院
四川大学
医院
亚硝胺
心脑血管病
血管内皮
胆固醇
接种疫苗
凝血因子
预防胃癌
中国传统文化
鼻咽癌
糖尿病酮症酸中毒
世界卫生组织
亚硝酸盐
icu
阿司匹林
溃疡性结肠炎
致癌物质
口腔癌
乙肝病毒
乙肝病毒携带者
乙肝
乙型肝炎
幽门螺杆菌
肺部
寄生虫
猪血
阿尔茨海默病
妈妈
紧身衣
癌变
胃病
心绞痛
哮喘
胃食管
反流
胃食管反流
鸡翅
香菜
白发
头皮
黑色素细胞
血液循环
腰膝酸软
北京中医药大学
心脑血管疾病
贴秋膘
核桃
李奶奶
肌肉痉挛
我们来了
大数据
甲状腺结节
肺结节
良性肿瘤
预防肿瘤
阿尔茨海默症
于无声处
中国人寿
保险
牙结石
南华大学
焦虑症
抑郁症
甲醛
心脏
血管堵塞
病毒感染
病毒
抗衰老
成瘾性
精子质量
中国科学院
蓝莓
预防肝硬化
他汀类药物
糖皮质激素
抗生素
动态平衡
碳酸饮料
简爱
走近科学
酵母
辅食
帕金森
肠胃疾病
单核细胞
是真的吗
头晕头痛